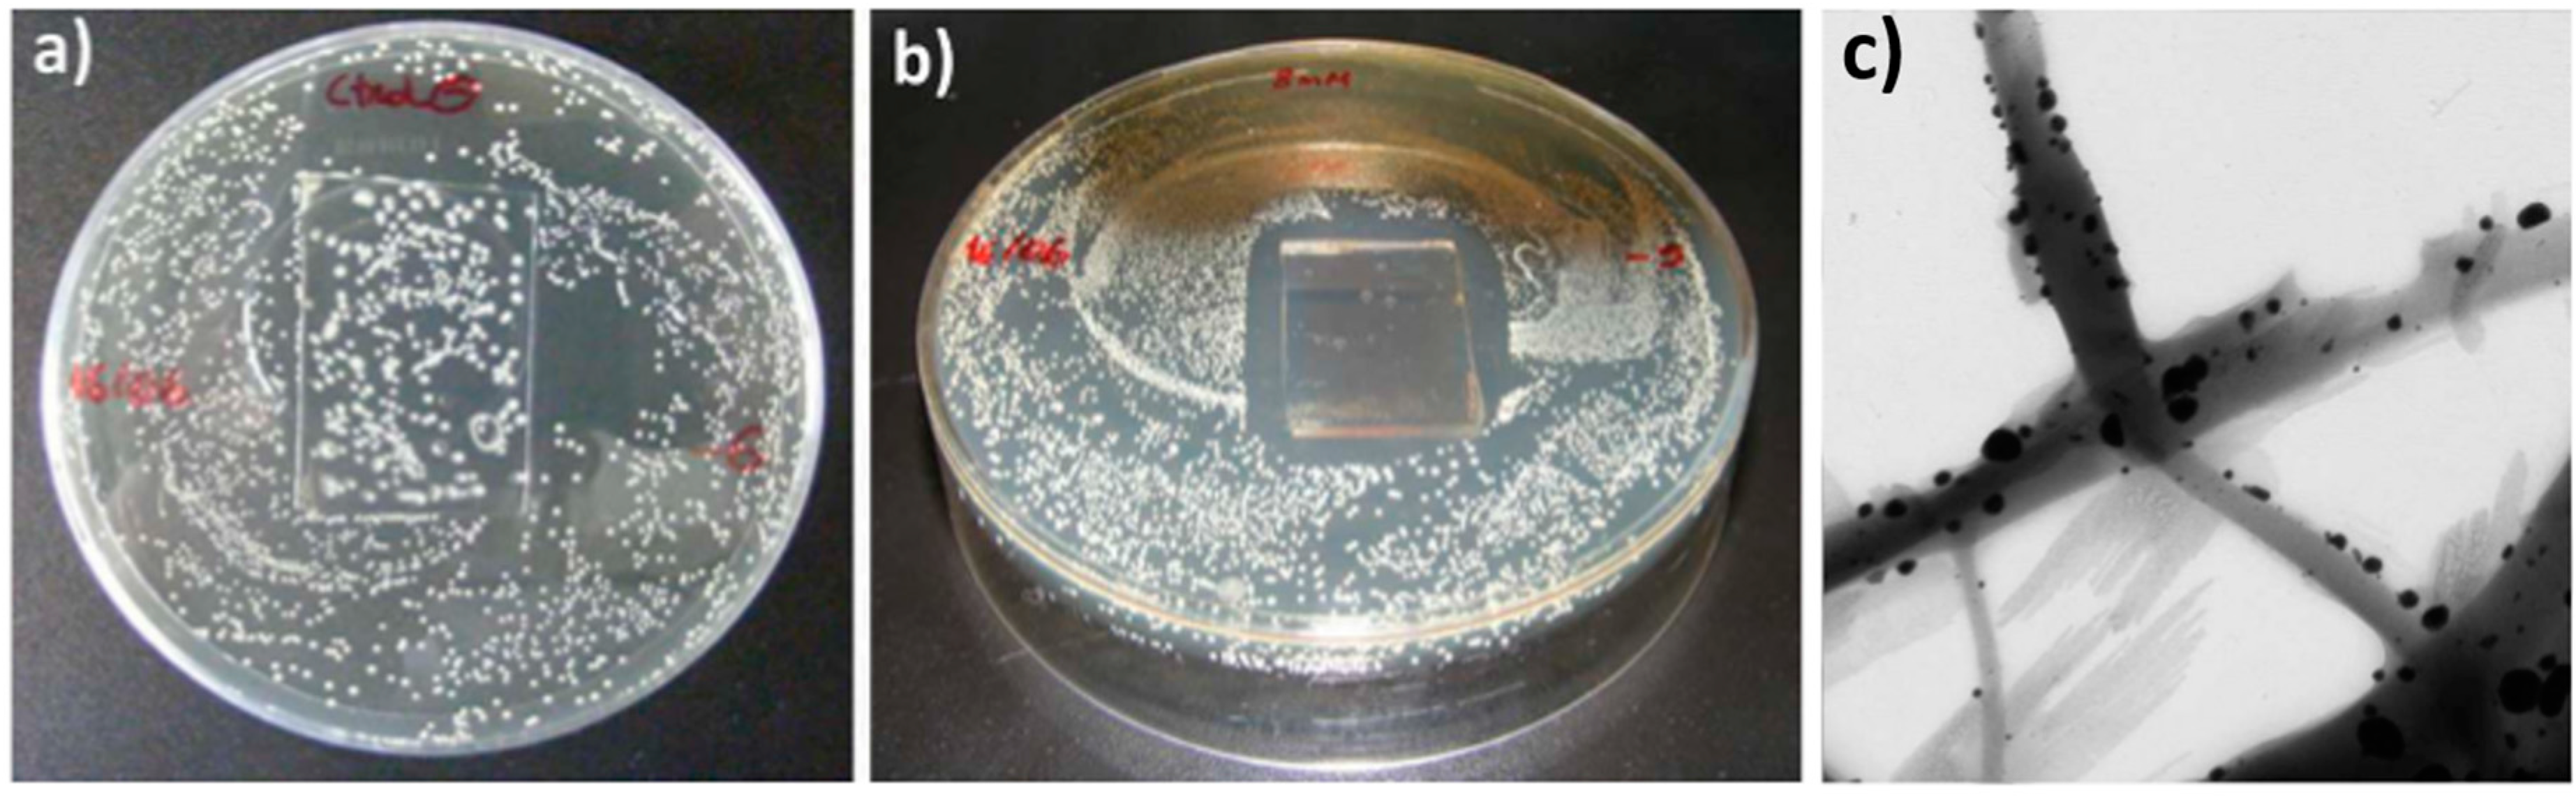
Coatings 08 00076 g008 Coatings 08 00076 g008

Design of Nanostructured Functional Coatings by Using Wet-Chemistry Methods
Abstract
1. Introduction
1.1. Nanofabrication Techniques for the Design of Functional Coatings
1.2. The Layer-by-Layer (LbL) Assembly
1.3. The Sol-Gel Dip-Coating Technology
1.4. Electrospinning Process
2. Nanostructured Functional Applications
2.1. Superhydrophobic Surfaces
2.2. Biocide Surface Treatments
2.3. Optical Fiber Sensors
3. Conclusions
Acknowledgments
Conflicts of Interest
References
- Bell, T. Surface engineering: A rapidly developing discipline. Eur. J. Eng. Educ. 1987, 12, 27–32. [Google Scholar] [CrossRef]
- Musil, J. Physical and mechanical properties of hard nanocomposite films prepared by reactive magnetron sputtering. In Nanostructured Coatings; Cavaleiro, A., de Hosson, J.T.M., Eds.; Springer: New York, NY, USA, 2006; pp. 407–463. [Google Scholar]
- Shinn, M.; Hultman, L.; Barnett, S.A. Growth, structure, and microhardness of epitaxial TiN/NbN superlattices. J. Mater. Res. 1992, 7, 901–911. [Google Scholar] [CrossRef]
- De Hosson, J.T.M.; Cavaleiro, A. Galileo comes to the surface! In Nanostructured Coatings; Springer: New York, NY, USA, 2006; pp. 1–26. [Google Scholar]
- Decher, G. Fuzzy nanoassemblies: Toward layered polymeric multicomposites. Science 1997, 277, 1232–1237. [Google Scholar] [CrossRef]
- Izquierdo, A.; Ono, S.S.; Voegel, J.-C.; Schaaf, P.; Decher, G. Dipping versus spraying: Exploring the deposition conditions for speeding up layer-by-layer assembly. Langmuir 2005, 21, 7558–7567. [Google Scholar] [CrossRef] [PubMed]
- Lavalle, P.; Gergely, C.; Cuisinier, F.J.G.; Decher, G.; Schaaf, P.; Voegel, J.C.; Picart, C. Comparison of the structure of polyelectrolyte multilayer films exhibiting a linear and an exponential growth regime: An in situ atomic force microscopy study. Macromolecules 2002, 35, 4458–4465. [Google Scholar] [CrossRef]
- Choi, J.; Rubner, M.F. Influence of the degree of ionization on weak polyelectrolyte multilayer assembly. Macromolecules 2005, 38, 116–124. [Google Scholar] [CrossRef]
- Shiratori, S.S.; Rubner, M.F. pH-dependent thickness behavior of sequentially adsorbed layers of weak polyelectrolytes. Macromolecules 2000, 33, 4213–4219. [Google Scholar] [CrossRef]
- Yoo, D.; Shiratori, S.S.; Rubner, M.F. Controlling bilayer composition and surface wettability of sequentially adsorbed multilayers of weak polyelectrolytes. Macromolecules 1998, 31, 4309–4318. [Google Scholar] [CrossRef]
- Derocher, J.P.; Mao, P.; Kim, J.Y.; Han, J.; Rubner, M.F.; Cohen, R.E. Layer-by-layer deposition of all-nanoparticle multilayers in confined geometries. ACS Appl. Mater. Interfaces 2012, 4, 391–396. [Google Scholar] [CrossRef] [PubMed]
- Du, Y.; Luna, L.E.; Tan, W.S.; Rubner, M.F.; Cohen, R.E. Hollow silica nanoparticles in UV-Visible antireflection coatings for poly(methyl methacrylate) substrates. ACS Nano 2010, 4, 4308–4316. [Google Scholar] [CrossRef] [PubMed]
- Nuraje, N.; Asmatulu, R.; Cohen, R.E.; Rubner, M.F. Durable antifog films from layer-by-layer molecularly blended hydrophilic polysaccharides. Langmuir 2011, 27, 782–791. [Google Scholar] [CrossRef] [PubMed]
- Goicoechea, J.; Zamarreño, C.R.; Matías, I.R.; Arregui, F.J. Optical fiber pH sensors based on layer-by-layer electrostatic self-assembled neutral red. Sens. Actuators B Chem. 2008, 132, 305–311. [Google Scholar] [CrossRef]
- Zamarreño, C.R.; Goicoechea, J.; Matías, I.R.; Arregui, F.J. Laterally selective adsorption of pH sensing coatings based on neutral red by means of the electric field directed layer-by-layer self-assembly method. Thin Solid Films 2009, 517, 3776–3780. [Google Scholar] [CrossRef]
- Ki Bae, W.; Kwak, J.; Lim, J.; Lee, D.; Ki Nam, M.; Char, K.; Lee, C.; Lee, S. Multicolored light-emitting diodes based on all-quantum-dot multilayer films using layer-by-layer assembly method. Nano Lett. 2010, 10, 2368–2373. [Google Scholar] [CrossRef] [PubMed]
- Xiao, F.-X.; Miao, J.; Liu, B. Layer-by-layer self-assembly of CdS quantum dots/graphene nanosheets hybrid films for photoelectrochemical and photocatalytic applications. J. Am. Chem. Soc. 2014, 136, 1559–1569. [Google Scholar] [CrossRef] [PubMed]
- Rivero, P.J.; Goicoechea, J.; Matias, I.R.; Arregui, F.J. A comparative study of two different approaches for the incorporation of silver nanoparticles into layer-by-layer films. Nanoscale Res. Lett. 2014, 9, 301. [Google Scholar] [CrossRef] [PubMed]
- Rivero, P.J.; Goicoechea, J.; Urrutia, A.; Matias, I.R.; Arregui, F.J. Multicolor layer-by-layer films using weak polyelectrolyte assisted synthesis of silver nanoparticles. Nanoscale Res. Lett. 2013, 8, 438. [Google Scholar] [CrossRef] [PubMed]
- Brinker, C.J.; Scherer, G.W. Sol-Gel Science: The Physics and Chemistry of Sol-Gel Processing; Academic Press: Cambridge, MA, USA, 2013. [Google Scholar]
- Brinker, C.J.; Scherer, G.W. Sol→gel→glass: I. Gelation and gel structure. J. Non-Cryst. Solids 1985, 70, 301–322. [Google Scholar] [CrossRef]
- Brinker, C.J.; Scherer, G.W.; Roth, E.P. Sol→gel→glass: II. Physical and structural evolution during constant heating rate experiments. J. Non-Cryst. Solids 1985, 72, 345–368. [Google Scholar] [CrossRef]
- Scherer, G.W.; Brinker, C.J.; Roth, E.P. Sol→gel→glass: III. Viscous sintering. J. Non-Cryst. Solids 1985, 72, 369–389. [Google Scholar] [CrossRef]
- Ying, J.Y.; Benziger, J.B. Structure tailoring of alkoxide silica. J. Non-Cryst. Solids 1992, 147, 222–231. [Google Scholar] [CrossRef]
- Ying, J.Y.; Benziger, J.B.; Navrotsky, A. Structural evolution of colloidal silica gels to glass. J. Am. Ceram. Soc. 1993, 76, 2561–2570. [Google Scholar] [CrossRef]
- Rivero, P.J.; Urrutia, A.; Goicoechea, J.; Zamarreño, C.R.; Arregui, F.J.; Matías, I.R. An antibacterial coating based on a polymer/sol-gel hybrid matrix loaded with silver nanoparticles. Nanoscale Res. Lett. 2011, 6, 305. [Google Scholar] [CrossRef] [PubMed]
- Doshi, J.; Reneker, D.H. Electrospinning process and applications of electrospun fibers. J. Electrost. 1995, 35, 151–160. [Google Scholar] [CrossRef]
- Burger, C.; Hsiao, B.S.; Chu, B. Nanofibrous materials and their applications. Ann. Rev. Mater. Res. 2006, 36, 333–368. [Google Scholar] [CrossRef]
- Luo, C.J.; Stoyanov, S.D.; Stride, E.; Pelan, E.; Edirisinghe, M. Electrospinning versus fibre production methods: From specifics to technological convergence. Chem. Soc. Rev. 2012, 41, 4708–4735. [Google Scholar] [CrossRef] [PubMed]
- Persano, L.; Camposeo, A.; Tekmen, C.; Pisignano, D. Industrial upscaling of electrospinning and applications of polymer nanofibers: A review. Macromol. Mater. Eng. 2013, 298, 504–520. [Google Scholar] [CrossRef]
- Shabafrooz, V.; Mozafari, M.; Vashaee, D.; Tayebi, L. Electrospun nanofibers: From filtration membranes to highly specialized tissue engineering scaffolds. J. Nanosci. Nanotechnol. 2014, 14, 522–534. [Google Scholar] [CrossRef] [PubMed]
- Zucchelli, A.; Focarete, M.L.; Gualandi, C.; Ramakrishna, S. Electrospun nanofibers for enhancing structural performance of composite materials. Polym. Adv. Technol. 2011, 22, 339–349. [Google Scholar] [CrossRef]
- Deitzel, J.M.; Kleinmeyer, J.; Harris, D.; Beck Tan, N.C. The effect of processing variables on the morphology of electrospun nanofibers and textiles. Polymer 2001, 42, 261–272. [Google Scholar] [CrossRef]
- Greiner, A.; Wendorff, J.H. Electrospinning: A Fascinating method for the preparation of ultrathin fibers. Angew. Chem. Int. Ed. 2007, 46, 5670–5703. [Google Scholar] [CrossRef] [PubMed]
- Wang, X.; Drew, C.; Lee, S.-H.; Senecal, K.J.; Kumar, J.; Samuelson, L.A. Electrospun nanofibrous membranes for highly sensitive optical sensors. Nano Lett. 2002, 2, 1273–1275. [Google Scholar] [CrossRef]
- Urrutia, A.; Goicoechea, J.; Rivero, P.J.; Matías, I.R.; Arregui, F.J. Electrospun nanofiber mats for evanescent optical fiber sensors. Sens. Actuators B Chem. 2013, 176, 569–576. [Google Scholar] [CrossRef]
- Wang, X.; Drew, C.; Lee, S.-H.; Senecal, K.J.; Kumar, J.; Samuelson, L.A. Electrospinning technology: A novel approach to sensor application. J. Macromol. Sci. Pure Appl. Chem. 2002, 39, 1251–1258. [Google Scholar] [CrossRef]
- Yao, X.; Song, Y.; Jiang, L. Applications of bio-inspired special wettable surfaces. Adv. Mater. 2011, 23, 719–734. [Google Scholar] [CrossRef] [PubMed]
- Rivero, P.J.; Urrutia, A.; Goicoechea, J.; Arregui, F.J. Nanomaterials for functional textiles and fibers. Nanoscale Res. Lett. 2015, 10, 501. [Google Scholar] [CrossRef] [PubMed]
- Lopez-Torres, D.; Elosua, C.; Hernaez, M.; Goicoechea, J.; Arregui, F.J. From superhydrophilic to superhydrophobic surfaces by means of polymeric layer-by-layer films. Appl. Surf. Sci. 2015, 351, 1081–1086. [Google Scholar] [CrossRef]
- Gao, L.; McCarthy, T.J. “Artificial lotus leaf” prepared using a 1945 patent and a commercial textile. Langmuir 2006, 22, 5998–6000. [Google Scholar] [CrossRef] [PubMed]
- Gao, Q.; Zhu, Q.; Guo, Y.; Yang, C.Q. Formation of highly hydrophobic surfaces on cotton and polyester fabrics using silica sol nanoparticles and nonfluorinated alkylsilane. Ind. Eng. Chem. Res. 2009, 48, 9797–9803. [Google Scholar] [CrossRef]
- Mazrouei-Sebdani, Z.; Khoddami, A. Alkaline hydrolysis: A facile method to manufacture superhydrophobic polyester fabric by fluorocarbon coating. Prog. Org. Coat. 2011, 72, 638–646. [Google Scholar] [CrossRef]
- Wang, H.; Ding, J.; Xue, Y.; Wang, X.; Lin, T. Superhydrophobic fabrics from hybrid silica sol-gel coatings: Structural effect of precursors on wettability and washing durability. J. Mater. Res. 2010, 25, 1336–1343. [Google Scholar] [CrossRef]
- Xu, L.; Shen, Y.; Wang, L.; Ding, Y.; Cai, Z. Preparation of vinyl silica-based organic/inorganic nanocomposites and superhydrophobic polyester surfaces from it. Colloid Polym. Sci. 2015, 293, 2359–2371. [Google Scholar] [CrossRef]
- Xu, L.; Cai, Z.; Shen, Y.; Wang, L.; Ding, Y. Facile preparation of superhydrophobic polyester surfaces with fluoropolymer/SiO2 nanocomposites based on vinyl nanosilica hydrosols. J. Appl. Polym. Sci. 2014, 131. [Google Scholar] [CrossRef]
- Berendjchi, A.; Khajavi, R.; Yazdanshenas, M.E. Fabrication of superhydrophobic and antibacterial surface on cotton fabric by doped silica-based sols with nanoparticles of copper. Nanoscale Res. Lett. 2011, 6, 594. [Google Scholar] [CrossRef] [PubMed]
- Zheng, S.; Li, J. Inorganic-organic sol-gel hybrid coatings for corrosion protection of metals. J. Sol Gel Sci. Technol. 2010, 54, 174–187. [Google Scholar] [CrossRef]
- Wang, D.; Bierwagen, G.P. Sol-gel coatings on metals for corrosion protection. Prog. Org. Coat. 2009, 64, 327–338. [Google Scholar] [CrossRef]
- Poznyak, S.K.; Zheludkevich, M.L.; Raps, D.; Gammel, F.; Yasakau, K.A.; Ferreira, M.G.S. Preparation and corrosion protective properties of nanostructured titania-containing hybrid sol-gel coatings on AA2024. Prog. Org. Coat. 2008, 62, 226–235. [Google Scholar] [CrossRef]
- Du, Y.J.; Damron, M.; Tang, G.; Zheng, H.; Chu, C.-J.; Osborne, J.H. Inorganic/organic hybrid coatings for aircraft aluminum alloy substrates. Prog. Org. Coat. 2001, 41, 226–232. [Google Scholar]
- Cairns, D.R.; Kessman, A.J.; Richter, P.J.; Bottari, F.J.; Randall, N.X. Mechanical and tribological investigations of sol-gel derived SiO2 optical coatings. Wear 2008, 265, 411–416. [Google Scholar] [CrossRef]
- Lakshmi, R.V.; Bharathidasan, T.; Basu, B.J. Superhydrophobic sol-gel nanocomposite coatings with enhanced hardness. Appl. Surf. Sci. 2011, 257, 10421–10426. [Google Scholar] [CrossRef]
- Lakshmi, R.V.; Bera, P.; Anandan, C.; Basu, B.J. Effect of the size of silica nanoparticles on wettability and surface chemistry of sol-gel superhydrophobic and oleophobic nanocomposite coatings. Appl. Surf. Sci. 2014, 320, 780–786. [Google Scholar] [CrossRef]
- Taurino, R.; Fabbri, E.; Pospiech, D.; Synytska, A.; Messori, M. Preparation of scratch resistant superhydrophobic hybrid coatings by sol-gel process. Prog. Org. Coat. 2014, 77, 1635–1641. [Google Scholar] [CrossRef]
- Liang, J.; Hu, Y.; Wu, Y.; Chen, H. Facile formation of superhydrophobic silica-based surface on aluminum substrate with tetraethylorthosilicate and vinyltriethoxysilane as co-precursor and its corrosion resistant performance in corrosive NaCl aqueous solution. Surf. Coat. Technol. 2014, 240, 145–153. [Google Scholar] [CrossRef]
- Wang, S.; Guo, X.; Xie, Y.; Liu, L.; Yang, H.; Zhu, R.; Gong, J.; Peng, L.; Ding, W. Preparation of superhydrophobic silica film on Mg-Nd-Zn-Zr magnesium alloy with enhanced corrosion resistance by combining micro-arc oxidation and sol-gel method. Surf. Coat. Technol. 2012, 213, 192–201. [Google Scholar] [CrossRef]
- Lai, D.; Kong, G.; Che, C. Synthesis and corrosion behavior of ZnO/SiO2 nanorod-sub microtube superhydrophobic coating on zinc substrate. Surf. Coat. Technol. 2017, 315, 509–518. [Google Scholar] [CrossRef]
- Yu, Q.; Xu, J. Structure and surface properties of fluorinated organic-inorganic hybrid films. J. Sol Gel Sci. Technol. 2012, 61, 243–248. [Google Scholar] [CrossRef]
- Caldarelli, A.; Raimondo, M.; Veronesi, F.; Boveri, G.; Guarini, G. Sol-gel route for the building up of superhydrophobic nanostructured hybrid-coatings on copper surfaces. Surf. Coat. Technol. 2015, 276, 408–415. [Google Scholar] [CrossRef]
- Liu, Y.; Chen, X.; Xin, J.H. Super-hydrophobic surfaces from a simple coating method: A bionic nanoengineering approach. Nanotechnology 2006, 17, 3259–3263. [Google Scholar] [CrossRef]
- Isimjan, T.T.; Wang, T.; Rohani, S. A novel method to prepare superhydrophobic, uv resistance and anti-corrosion steel surface. Chem. Eng. J. 2012, 210, 182–187. [Google Scholar] [CrossRef]
- Maeztu, J.D.; Rivero, P.J.; Berlanga, C.; Bastidas, D.M.; Palacio, J.F.; Rodriguez, R. Effect of graphene oxide and fluorinated polymeric chains incorporated in a multilayered sol-gel nanocoating for the design of corrosion resistant and hydrophobic surfaces. Appl. Surf. Sci. 2017, 419, 138–149. [Google Scholar] [CrossRef]
- Zheludkevich, M.L.; Serra, R.; Montemor, M.F.; Miranda Salvado, I.M.; Ferreira, M.G.S. Corrosion protective properties of nanostructured sol-gel hybrid coatings to AA2024-T3. Surf. Coat. Technol. 2006, 200, 3084–3094. [Google Scholar] [CrossRef]
- Pepe, A.; Aparicio, M.; Ceré, S.; Durán, A. Preparation and characterization of cerium doped silica sol-gel coatings on glass and aluminum substrates. J. Non-Cryst. Solids 2004, 348, 162–171. [Google Scholar] [CrossRef]
- Zaharescu, M.; Predoana, L.; Barau, A.; Raps, D.; Gammel, F.; Rosero-Navarro, N.C.; Castro, Y.; Durán, A.; Aparicio, M. SiO2 based hybrid inorganic-organic films doped with TiO2-CeO2 nanoparticles for corrosion protection of AA2024 and Mg-AZ31B alloys. Corros. Sci. 2009, 51, 1998–2005. [Google Scholar] [CrossRef]
- Liang, Y.; Wang, M.D.; Wang, C.; Feng, J.; Li, J.S.; Wang, L.J.; Fu, J.J. Facile synthesis of smart nanocontainers as key components for construction of self-healing coating with superhydrophobic surfaces. Nanoscale Res. Lett. 2016, 11, 231. [Google Scholar] [CrossRef] [PubMed]
- Skorb, E.V.; Andreeva, D.V. Self-healing properties of layer-by-layer assembled multilayers. Polym. Int. 2015, 64, 713–723. [Google Scholar] [CrossRef]
- Andreeva, D.V.; Fix, D.; Möhwald, H.; Shchukin, D.G. Self-healing anticorrosion coatings based on pH-sensitive polyelectrolyte/inhibitor sandwichlike nanostructures. Adv. Mater. 2008, 20, 2789–2794. [Google Scholar] [CrossRef] [PubMed]
- Borodina, T.N.; Grigoriev, D.O.; Andreeva, D.V.; Möhwald, H.; Shchukin, D.G. Polyelectrolyte multilayered nanofilms as a novel approach for the protection of hydrogen storage materials. ACS Appl. Mater. Interfaces 2009, 1, 996–1001. [Google Scholar] [CrossRef] [PubMed]
- Li, Y.; Li, L.; Sun, J. Bioinspired self-healing superhydrophobic coatings. Angew. Chem. Int. Ed. 2010, 49, 6129–6133. [Google Scholar] [CrossRef] [PubMed]
- Manna, U.; Lynn, D.M. Restoration of superhydrophobicity in crushed polymer films by treatment with water: Self-healing and recovery of damaged topographic features aided by an unlikely source. Adv. Mater. 2013, 25, 5104–5108. [Google Scholar] [CrossRef] [PubMed]
- Radwan, A.B.; Mohamed, A.M.A.; Abdullah, A.M.; Al-Maadeed, M.A. Corrosion protection of electrospun PVDF-ZnO superhydrophobic coating. Surf. Coat. Technol. 2016, 289, 136–143. [Google Scholar] [CrossRef]
- Zhao, Y.; Xing, C.; Zhang, Z.; Yu, L. Superhydrophobic polyaniline/polystyrene micro/nanostructures as anticorrosion coatings. React. Funct. Polym. 2017, 119, 95–104. [Google Scholar] [CrossRef]
- Zhao, Y.; Zhang, Z.; Yu, L.; Jiang, T. hydrophobic polystyrene/electro-spun polyaniline coatings for corrosion protection. Synth. Met. 2017, 234, 166–174. [Google Scholar] [CrossRef]
- Zhao, Y.; Zhang, Z.; Yu, L. Corrosion protection of carbon steel by electrospun film containing polyaniline microfibers. React. Funct. Polym. 2016, 102, 20–26. [Google Scholar] [CrossRef]
- Zhao, Y.; Zhang, Z.; Yu, L.; Tang, Q. Electrospinning of polyaniline microfibers for anticorrosion coatings: An avenue of enhancing anticorrosion behaviors. Synth. Met. 2016, 212, 84–90. [Google Scholar] [CrossRef]
- Donlan, R.M.; Costerton, J.W. Biofilms: Survival mechanisms of clinically relevant microorganisms. Clin. Microbiol. Rev. 2002, 15, 167–193. [Google Scholar] [CrossRef] [PubMed]
- Hajipour, M.J.; Fromm, K.M.; Akbar Ashkarran, A.; Jimenez de Aberasturi, D.; Larramendi, I.R.D.; Rojo, T.; Serpooshan, V.; Parak, W.J.; Mahmoudi, M. Antibacterial properties of nanoparticles. Trends Biotechnol. 2012, 30, 499–511. [Google Scholar] [CrossRef] [PubMed]
- Mah, T.-F.C.; O’Toole, G.A. Mechanisms of biofilm resistance to antimicrobial agents. Trends Microbiol. 2001, 9, 34–39. [Google Scholar] [CrossRef]
- Monteiro, D.R.; Gorup, L.F.; Takamiya, A.S.; Ruvollo-Filho, A.C.; Camargo, E.R.D.; Barbosa, D.B. The growing importance of materials that prevent microbial adhesion: antimicrobial effect of medical devices containing silver. Int. J. Antimicrob. Agents 2009, 34, 103–110. [Google Scholar] [CrossRef] [PubMed]
- Rivero, P.J.; Urrutia, A.; Goicoechea, J.; Rodríguez, Y.; Corres, J.M.; Arregui, F.J.; Matías, I.R. An antibacterial submicron fiber mat with in situ synthesized silver nanoparticles. J. Appl. Polym. Sci. 2012, 126, 1228–1235. [Google Scholar] [CrossRef]
- Falletta, E.; Bonini, M.; Fratini, E.; Lo Nostro, A.; Pesavento, G.; Becheri, A.; Lo Nostro, P.; Canton, P.; Baglioni, P. Clusters of poly(acrylates) and silver nanoparticles: structure and applications for antimicrobial fabrics. J. Phys. Chem. C 2008, 112, 11758–11766. [Google Scholar] [CrossRef]
- Timin, A.; Rumyantsev, E. Silver-Silica Nanocomposite materials incorporated into textile fabrics: Chemical and biological study. BioNanoScience 2013, 3, 415–422. [Google Scholar] [CrossRef]
- Mahltig, B.; Fiedler, D.; Simon, P. Silver-containing sol-gel coatings on textiles: Antimicrobial effect as a function of curing treatment. J. Text. Inst. 2011, 102, 739–745. [Google Scholar] [CrossRef]
- Mahltig, B.; Textor, T. Silver containing sol-gel coatings on polyamide fabrics as antimicrobial finish-description of a technical application process for wash permanent antimicrobial effect. Fibers Polym. 2010, 11, 1152–1158. [Google Scholar] [CrossRef]
- Mihailovic, D.; Šaponjic, Z.; Vodnik, V.; Potkonjak, B.; Jovancic, P.; Nedeljkovic, J.M.; Radetic, M. Multifunctional PES fabrics modified with colloidal Ag and TiO2 nanoparticles. Polym. Adv. Technol. 2011, 22, 2244–2249. [Google Scholar] [CrossRef]
- Radetic, M. Functionalization of textile materials with TiO2 nanoparticles. J. Photochem. Photobiol. C Photochem. Rev. 2013, 16, 62–76. [Google Scholar] [CrossRef]
- Khurana, N.; Adivarekar, R.V. Effect of dispersing agents on synthesis of nano titanium oxide and its application for antimicrobial property. Fibers Polym. 2013, 14, 1094–1100. [Google Scholar] [CrossRef]
- Azam, A.; Ahmed, A.S.; Oves, M.; Khan, M.S.; Habib, S.S.; Memic, A. Antimicrobial activity of metal oxide nanoparticles against gram-positive and gram-negative bacteria: A comparative Study. Int. J. Nanomed. 2012, 7, 6003–6009. [Google Scholar] [CrossRef] [PubMed]
- Farouk, A.; Moussa, S.; Ulbricht, M.; Schollmeyer, E.; Textor, T. ZnO-modified hybrid polymers as an antibacterial finish for textiles. Text. Res. J. 2014, 84, 40–51. [Google Scholar] [CrossRef]
- Mahltig, B.; Fiedler, D.; Böttcher, H. Antimicrobial sol-gel coatings. J. Sol Gel Sci. Technol. 2004, 32, 219–222. [Google Scholar] [CrossRef]
- Urrutia, A.; Rivero, P.J.; Ruete, L.; Goicoechea, J.; Fernández-Valdivieso, C.; Arregui, F.J.; Matías, I.R. An antibacterial surface coating composed of PAH/SiO2 nanostructurated films by layer by layer. Phys. Status Solidi c 2010, 7, 2774–2777. [Google Scholar] [CrossRef]
- Urrutia, A.; Rivero, P.J.; Ruete, L.; Goicoechea, J.; Matías, I.R.; Arregui, F.J. Single-stage in situ synthesis of silver nanoparticles in antibacterial self-assembled overlays. Colloid Polym. Sci. 2012, 290, 785–792. [Google Scholar] [CrossRef]
- Whitehouse, J.D.; Friedman, N.D.; Kirkland, K.B.; Richardson, W.J.; Sexton, D.J. The impact of surgical-site infections following orthopedic surgery at a community hospital and a university hospital: Adverse quality of life, excess length of stay, and extra cost. Infect. Control Hosp. Epidemiol. 2002, 23, 183–189. [Google Scholar] [CrossRef] [PubMed]
- Stoodley, P.; Ehrlich, G.D.; Sedghizadeh, P.P.; Hall-Stoodley, L.; Baratz, M.E.; Altman, D.T.; Sotereanos, N.G.; Costerton, J.W.; DeMeo, P. Orthopaedic biofilm infections. Curr. Orthop. Pract. 2011, 22, 558–563. [Google Scholar] [CrossRef] [PubMed]
- Laverty, G.; Gorman, S.P.; Gilmore, B.F. Biomolecular mechanisms of staphylococcal biofilm formation. Future Microbiol. 2013, 8, 509–524. [Google Scholar] [CrossRef] [PubMed]
- Foster, T.J.; Geoghegan, J.A.; Ganesh, V.K.; Höök, M. Adhesion, invasion and evasion: The many functions of the surface proteins of staphylococcus aureus. Nat. Rev. Microbiol. 2014, 12, 49–62. [Google Scholar] [CrossRef] [PubMed]
- Romanò, C.L.; Scarponi, S.; Gallazzi, E.; Romanò, D.; Drago, L. Antibacterial coating of implants in orthopaedics and trauma: A classification proposal in an evolving panorama. J. Orthop. Surg. Res. 2015, 10, 157. [Google Scholar] [CrossRef] [PubMed]
- Glinel, K.; Thebault, P.; Humblot, V.; Pradier, C.M.; Jouenne, T. Antibacterial surfaces developed from bio-inspired approaches. Acta Biomater. 2012, 8, 1670–1684. [Google Scholar] [CrossRef] [PubMed]
- Ivanova, E.P.; Hasan, J.; Webb, H.K.; Gervinskas, G.; Juodkazis, S.; Truong, V.K.; Wu, A.H.F.; Lamb, R.N.; Baulin, V.A.; Watson, G.S.; et al. Bactericidal activity of black silicon. Nat. Commun. 2013, 4, 2838. [Google Scholar] [CrossRef] [PubMed]
- Diu, T.; Faruqui, N.; Sjöström, T.; Lamarre, B.; Jenkinson, H.F.; Su, B.; Ryadnov, M.G. Cicada-inspired cell-instructive nanopatterned arrays. Sci. Rep. 2014, 4, 7122. [Google Scholar] [CrossRef] [PubMed]
- Fadeeva, E.; Truong, V.K.; Stiesch, M.; Chichkov, B.N.; Crawford, R.J.; Wang, J.; Ivanova, E.P. Bacterial retention on superhydrophobic titanium surfaces fabricated by femtosecond laser ablation. Langmuir 2011, 27, 3012–3019. [Google Scholar] [CrossRef] [PubMed]
- Valle, J.; Burgui, S.; Langheinrich, D.; Gil, C.; Solano, C.; Toledo-Arana, A.; Helbig, R.; Lasagni, A.; Lasa, I. Evaluation of surface microtopography engineered by direct laser interference for bacterial anti-biofouling. Macromol. Biosci. 2015, 15, 1060–1069. [Google Scholar] [CrossRef] [PubMed]
- Puckett, S.D.; Taylor, E.; Raimondo, T.; Webster, T.J. The relationship between the nanostructure of titanium surfaces and bacterial attachment. Biomaterials 2010, 31, 706–713. [Google Scholar] [CrossRef] [PubMed]
- Ploux, L.; Anselme, K.; Dirani, A.; Ponche, A.; Soppera, O.; Roucoules, V. Opposite responses of cells and bacteria to micro/nanopatterned surfaces prepared by pulsed plasma polymerization and UV-irradiation. Langmuir 2009, 25, 8161–8169. [Google Scholar] [CrossRef] [PubMed]
- Freschauf, L.R.; McLane, J.; Sharma, H.; Khine, M. Shrink-induced superhydrophobic and antibacterial surfaces in consumer plastics. PLoS ONE 2012, 7, e40987. [Google Scholar] [CrossRef] [PubMed]
- Culshaw, B. Optical fiber sensor technologies: Opportunities and-perhaps-pitfalls. J. Light. Technol. 2004, 22, 39–50. [Google Scholar] [CrossRef]
- Culshaw, B.; Kersey, A. Fiber-optic sensing: A historical perspective. J. Light. Technol. 2008, 26, 1064–1078. [Google Scholar] [CrossRef]
- Culshaw, B.; Stewart, G.; Dong, F.; Tandy, C.; Moodie, D. Fibre optic techniques for remote spectroscopic methane detection—From concept to system realisation. Sens. Actuators B Chem. 1998, 51, 25–37. [Google Scholar] [CrossRef]
- Borisov, S.M.; Wolfbeis, O.S. Optical Biosensors. Chem. Rev. 2008, 108, 423–461. [Google Scholar] [CrossRef] [PubMed]
- Oehme, I.; Wolfbeis, O.S. Optical sensors for determination of heavy metal ions. Mikrochim. Acta 1997, 126, 177–192. [Google Scholar] [CrossRef]
- Corres, J.M.; Del Villar, I.; Matias, I.R.; Arregui, F.J. Two-layer nanocoatings in long-period fiber gratings for improved sensitivity of humidity sensors. IEEE Trans. Nanotechnol. 2008, 7, 394–400. [Google Scholar] [CrossRef]
- Corres, J.M.; Matias, I.R.; del Villar, I.; Arregui, F.J. Design of pH sensors in long-period fiber gratings using polymeric nanocoatings. IEEE Sens. J. 2007, 7, 455–463. [Google Scholar] [CrossRef]
- Gu, B.; Yin, M.-J.; Zhang, A.P.; Qian, J.-W.; He, S. Low-cost high-performance fiber-optic pH sensor based on thin-core fiber modal interferometer. Opt. Express 2009, 17, 22296–22302. [Google Scholar] [CrossRef] [PubMed]
- Simões, E.; Abe, I.; Oliveira, J.; Frazão, O.; Caldas, P.; Pinto, J.L. Characterization of optical fiber long period grating refractometer with nanocoating. Sens. Actuators B Chem. 2011, 153, 335–339. [Google Scholar] [CrossRef]
- Smietana, M.; Bock, W.J.; Mikulic, P. Temperature sensitivity of silicon nitride nanocoated long-period gratings working in various surrounding media. Meas. Sci. Technol. 2011, 22, 115203. [Google Scholar] [CrossRef]
- Yarimaga, O.; Jaworski, J.; Yoon, B.; Kim, J.-M. Polydiacetylenes: Supramolecular smart materials with a structural hierarchy for sensing, imaging and display applications. Chem. Commun. 2012, 48, 2469–2485. [Google Scholar] [CrossRef] [PubMed]
- Yin, M.; Gu, B.; Zhao, Q.; Qian, J.; Zhang, A.; An, Q.; He, S. Highly sensitive and fast responsive fiber-optic modal interferometric pH sensor based on polyelectrolyte complex and polyelectrolyte self-assembled nanocoating. Anal. Bioanal. Chem. 2011, 399, 3623–3631. [Google Scholar] [CrossRef] [PubMed]
- Zamarreño, C.R.; Hernáez, M.; Del Villar, I.; Matías, I.R.; Arregui, F.J. Optical fiber pH sensor based on lossy-mode resonances by means of thin polymeric coatings. Sens. Actuators B Chem. 2011, 155, 290–297. [Google Scholar] [CrossRef]
- Korposh, S.; James, S.W.; Lee, S.-W.; Topliss, S.; Cheung, S.C.; Batty, W.J.; Tatam, R.P. Fiber optic long period grating sensors with a nanoassembled mesoporous film of SiO2 nanoparticles. Opt. Express 2010, 18, 13227–13238. [Google Scholar] [CrossRef] [PubMed]
- Yang, X.; Salles, V.; Kaneti, Y.V.; Liu, M.; Maillard, M.; Journet, C.; Jiang, X.; Brioude, A. Fabrication of highly sensitive gas sensor based on au functionalized WO3 composite nanofibers by electrospinning. Sens. Actuators B Chem. 2015, 220, 1112–1119. [Google Scholar] [CrossRef]
- Chu, C.-S.; Lo, Y.-L. Optical fiber dissolved oxygen sensor based on Pt(II) complex and core-shell silica nanoparticles incorporated with sol-gel matrix. Sens. Actuators B Chem. 2010, 151, 83–89. [Google Scholar] [CrossRef]
- Corres, J.M.; Matias, I.R.; Hernaez, M.; Bravo, J.; Arregui, F.J. Optical fiber humidity sensors using nanostructured coatings of SiO2 nanoparticles. IEEE Sens. J. 2008, 8, 281–285. [Google Scholar] [CrossRef]
- Viegas, D.; Hernaez, M.; Goicoechea, J.; Santos, J.L.; Araújo, F.M.; Arregui, F.; Matias, I.R. Simultaneous measurement of humidity and temperature based on an Sio2-nanospheres film deposited on a long-period grating in-line with a fiber bragg grating. IEEE Sens. J. 2011, 11, 162–166. [Google Scholar] [CrossRef]
- Hernáez, M.; Villar, I.D.; Zamarreño, C.R.; Arregui, F.J.; Matias, I.R. Optical fiber refractometers based on lossy mode resonances supported by TiO2 coatings. Appl. Opt. 2010, 49, 3980–3985. [Google Scholar] [CrossRef] [PubMed]
- Liz-Marzán, L.M. Nanometals: Formation and color. Mater. Today 2004, 7, 26–31. [Google Scholar] [CrossRef]
- Liz-Marzán, L.M. Tailoring surface plasmons through the morphology and assembly of metal nanoparticles. Langmuir 2006, 22, 32–41. [Google Scholar] [CrossRef] [PubMed]
- Rivero, P.J.; Goicoechea, J.; Urrutia, A.; Arregui, F.J. Effect of both protective and reducing agents in the synthesis of multicolor silver nanoparticles. Nanoscale Res. Lett. 2013, 8, 101. [Google Scholar] [CrossRef] [PubMed]
- Elosua, C.; Arregui, F.J.; del Villar, I.; Ruiz-Zamarreño, C.; Corres, J.M.; Bariain, C.; Goicoechea, J.; Hernaez, M.; Rivero, P.J.; Socorro, A.B.; et al. Micro and nanostructured materials for the development of optical fibre sensors. Sensors 2017, 17, 2312. [Google Scholar] [CrossRef] [PubMed]
- Lin, T.-J.; Chung, M.-F. Detection of cadmium by a fiber-optic biosensor based on localized surface plasmon resonance. Biosens. Bioelectron. 2009, 24, 1213–1218. [Google Scholar] [CrossRef] [PubMed]
- Chau, L.-K.; Lin, Y.-F.; Cheng, S.-F.; Lin, T.-J. Fiber-optic chemical and biochemical probes based on localized surface plasmon resonance. Sens. Actuators B Chem. 2006, 113, 100–105. [Google Scholar] [CrossRef]
- Lin, T.-J.; Chung, M.-F. Using monoclonal antibody to determine lead ions with a localized surface plasmon resonance fiber-optic biosensor. Sensors 2008, 8, 582–593. [Google Scholar] [CrossRef] [PubMed]
- Mitsui, K.; Handa, Y.; Kajikawa, K. Optical fiber affinity biosensor based on localized surface plasmon resonance. Appl. Phys. Lett. 2004, 85, 4231–4233. [Google Scholar] [CrossRef]
- Daniel, M.-C.; Astruc, D. Gold nanoparticles: assembly, supramolecular chemistry, quantum-size-related properties, and applications toward biology, catalysis, and nanotechnology. Chem. Rev. 2004, 104, 293–346. [Google Scholar] [CrossRef] [PubMed]
- Lin, C.-A.J.; Yang, T.-Y.; Lee, C.-H.; Huang, S.H.; Sperling, R.A.; Zanella, M.; Li, J.K.; Shen, J.-L.; Wang, H.-H.; Yeh, H.-I.; et al. Synthesis, characterization, and bioconjugation of fluorescent gold nanoclusters toward biological labeling applications. ACS Nano 2009, 3, 395–401. [Google Scholar] [CrossRef] [PubMed]
- Chen, I.-L.; Lin, S.-S.; Lin, T.-J.; Du, J.-K. Detection of hydrofluoric acid by a SiO2 sol-gel coating fiber-optic probe based on reflection-based localized surface plasmon resonance. Sensors 2011, 11, 1907–1923. [Google Scholar] [CrossRef] [PubMed]
- Jia, S.; Bian, C.; Tong, J.-H.; Sun, J.-Z.; Xia, S.-H. A localized surface plasmon resonance DNA biosensor based on gold nanospheres coated on the tip of the fiber. Optoelectron. Lett. 2016, 12, 157–160. [Google Scholar] [CrossRef]
- Wan, M.; Luo, P.; Jin, J.; Xing, J.; Wang, Z.; Wong, S.T.C. Fabrication of localized surface plasmon resonance fiber probes using ionic self-assembled gold nanoparticles. Sensors 2010, 10, 6477–6487. [Google Scholar] [CrossRef] [PubMed]
- Shao, Y.; Xu, S.; Zheng, X.; Wang, Y.; Xu, W. Optical fiber LSPR biosensor prepared by gold nanoparticle assembly on polyelectrolyte multilayer. Sensors 2010, 10, 3585–3596. [Google Scholar] [CrossRef] [PubMed]
- Budy, S.M.; Hamilton, D.J.; Cai, Y.; Knowles, M.K.; Reed, S.M. Polymer mediated layer-by-layer assembly of different shaped gold nanoparticles. J. Colloid Interface Sci. 2017, 487, 336–347. [Google Scholar] [CrossRef] [PubMed]
- Fu, Y.; Xu, H.; Bai, S.; Qiu, D.; Sun, J.; Wang, Z.; Zhang, X. Fabrication of a stable polyelectrolyte/Au nanoparticles multilayer film. Macromol. Rapid Commun. 2002, 23, 256–259. [Google Scholar] [CrossRef]
- Malikova, N.; Pastoriza-Santos, I.; Schierhorn, M.; Kotov, N.A.; Liz-Marzán, L.M. Layer-by-layer assembled mixed spherical and planar gold nanoparticles: control of interparticle interactions. Langmuir 2002, 18, 3694–3697. [Google Scholar] [CrossRef]
- Rivero, P.J.; Urrutia, A.; Goicoechea, J.; Arregui, F.J. Optical fiber humidity sensors based on localized surface plasmon resonance (LSPR) and lossy-mode resonance (LMR) in overlays loaded with silver nanoparticles. Sens. Actuators B Chem. 2012, 173, 244–249. [Google Scholar] [CrossRef]
- Rivero, P.J.; Hernaez, M.; Goicoechea, J.; Matias, I.R.; Arregui, F.J. Optical fiber refractometers based on localized surface plasmon resonance (LSPR) and lossy mode resonance (LMR). In 23rd International Conference on Optical Fibre Sensors, Proceedings of OFS2014 23rd International Conference on Optical Fiber Sensors, Santander, Spain, 2–6 June 2014; López-Higuera, J.M., Jones, J.D.C., López-Amo, M., Santos, J.L., Eds.; SPIE: Bellingham, WA, USA, 2014. [Google Scholar]
- Urrutia, A.; Goicoechea, J.; Rivero, P.J.; Pildain, A.; Arregui, F.J. Optical fiber sensors based on gold nanorods embedded in polymeric thin films. Sens. Actuators B Chem. 2018, 255, 2105–2112. [Google Scholar] [CrossRef]
- Rivero, P.J.; Goicoechea, J.; Hernaez, M.; Socorro, A.B.; Matias, I.R.; Arregui, F.J. Optical fiber resonance-based pH sensors using gold nanoparticles into polymeric layer-by-layer coatings. Microsyst. Technol. 2016, 22, 1821–1829. [Google Scholar] [CrossRef]
- Socorro, A.B.; Rivero, P.J.; Hernaez, M.; Goicoechea, J.; Matias, I.R.; Arregui, F.J. Optical fiber pH sensor based on gold nanoparticles into polymeric coatings. In Smart Sensors, Actuators, and MEMS VII; and Cyber Physical Systems, Proceedings of SPIE Microtechnologies, Barcelona, Spain, 8–10 May 2015; Sánchez-Rojas, J.L., Brama, R., Eds.; SPIE: Bellingham, WA, USA, 2014. [Google Scholar]
- Rivero, P.J.; Urrutia, A.; Goicoechea, J.; Matias, I.R.; Arregui, F.J. A lossy mode resonance optical sensor using silver nanoparticles-loaded films for monitoring human breathing. Sens. Actuators B Chem. 2013, 187, 40–44. [Google Scholar] [CrossRef]
- Del Villar, I.; Zamarreño, C.R.; Hernaez, M.; Arregui, F.J.; Matias, I.R. Generation of lossy mode resonances with absorbing thin-films. J. Light. Technol. 2010, 28, 3351–3357. [Google Scholar] [CrossRef]

| Technique | Advantages | Disadvantages | Final Structure |
|---|---|---|---|
| LbL assembly | A simple and versatile technique; Different substrates can be coated (metals, plastics, ceramics or even semiconductors) with different shapes and sizes; A repetitive and highly reproducible method; An easily scalable method, though time-consuming, for multilayer fabrication and industrial applications; No requirement of highly sophisticated materials or apparatus; It is carried out at room conditions; A good alternative to encapsulate a wide variety of chemical substances (indicators, nanoparticles, luminescent materials, quantum dots). | Only valid for water-soluble molecules (polyelectrolytes); Fabrication of soft coatings; Fabrication process can be long for thicker coatings as a function of the immersion time in the polyelectrolyte solutions and the final number of bilayers. | The final thickness and the surface properties can be tuned in a precise manner as function of the number of bilayers, concentration of the solution, pH and the ionic strength of the polyelectrolytes. |
| Sol-gel dip-coating technique | No sophisticated equipment (dip-coater); A good alternative to entrap molecules, enzymes or antibodies; Low-cost, flexible, simple and non-hazardous method for preparing coatings with controllable composition and microstructure; Excellent adhesion to the substrate; Possibility of obtaining a high variety of sol-gel derived materials as a function of the initial metal-alkoxyde precursor. Design of hybrid coatings makes possible to combine organic and inorganic properties; Fabrication of hard coatings with a high resistance to thermal or photo-chemical degradation. | The lack of a precise film thickness control up to 200 nm; Long aging time for the preparation of the sol-gel solution precursors; Curing step needs a moderate or high temperature to form a denser cross-linked coating. | The pulling up speed determines the resultant thickness coating; Depending on sol-gel processing parameters such as molecular precursor, water to silane ratio, nature of the catalyst, sol aging time and temperature; Acid-catalyzed reactions promote the formation of linear polymers; Basic-catalyzed reactions promote the formation of highly cross-linked polymers. |
| Electrospining process | Nanofibers provide a high surface area to volume ratio, and a high length to diameter ratio; A rapid fabrication process; Useful in a wide variety of industrial applications (separation membranes, artificial blood vessel or wound dressing materials). | Sophisticated equipment; Fabrication of soft coatings; Only valid for the production of synthetic fibers from polymeric solutions; A strict control of the solution properties (viscosity, surface tension, conductivity); the hydrostatic pressure in the capillarity; electrical potential at the tip of the needle and the distance between the tip and the collection screen. | Depending on the fabrication parameters, the electrospun fibers may have small diameters, ranging from 5 to 0.005 microns. |
| Precursor | Applications and Functional Characteristics |
|---|---|
| Sol-gel precursor (alkaline condition) | Cotton and polyester fabrics; high resistant of multiple washing cycles [42] |
| Sol-gel precursor (alkaline hydrolysis) | Polyester fabrics; any adverse effect on the samples tensile strength, abrasion resistance, as well as permeability to air [43] |
| Hybrid silica sol-gel coatings (alkaline conditions); Organic silanes with non-hydrolyzable functional groups (alkyl, fluorinated alkyl and phenyl) | Commercial polyester, wool and cotton fabrics; the presence of epoxide groups improves the washing durability [44] |
| Fluoropolymer/silica organic/inorganic nanocomposite | Flexible polyester fabrics; excellent superhydrophobicity [45] |
| Fluoropolymer/silica nanocomposite | Polyester fabrics; excellent superhydrophobicity [46] |
| Sol-gel precursor and use of copper nanoparticles | Cotton fabrics; multifunctionality (superhydrophobic and antibacterial surface) [47] |
| Hybrid sol-gel coating | Aluminum substrates; multifunctionality (superhydrophobic and high corrosion resistance) [56] |
| Combination of micro-arc oxidation and sol-gel process | Magnesium alloy; multifunctionality (superhydrophobic and enhanced corrosion resistance) [57] |
| Combination of hydrothermal and sol-gel process | Zinc substrate; multifunctionality (superhydrophobic and good corrosion resistance) [58] |
| Flower like alumina obtained by sol-gel process and fluoroalkylsilane | Copper surfaces; a high repellent behavior as a function of thermal treatment [60] |
| layer-by-layer method by using both TiO2 and SiO2 nanoparticles; further modification with a fluoro compound | Steel surfaces; strong repulsive force to water droplets; multifunctionality (superhydrophobic, UV resistance and anti-corrosion properties) [62] |
| Multilayered sol-gel nanocoatings based on graphene oxide and fluorinated polymeric chains | Aluminum alloy (6061T6); multifunctionality (high hydrophobic behavior; anticorrosion properties and good scratch-resistance) [63] |
| Smart nanocontainers with a special acid/alkali dual-stimuli release property | Aluminum alloy; multifunctionality (self-healing and superhydrophobic surfaces) [67] |
| layer-by-layer assembly | Non-flat substrates of aluminum heat sink; multifunctionality (self-healing and superhydrophobic surfaces) [71] |
| Electrospun PVDF-ZnO | Aluminum substrate; multifunctionality (superhydrophobic behavior and corrosion protection) [73] |
| Electrospun PS | Carbon steel; multifunctionality (superhydrophobic behavior and excellent anticorrosion protection) [74] |
| Electrospun PANI-PMMA | Carbon steel sheet; excellent protection performance with a highly hydrophobic behavior [75] |
| Antibacterial Agent | Antibacterial Test | Deposition Method |
|---|---|---|
| Silver nanoparticles (in situ synthesis by a chemical reduction method) | Lactobacillus plantarum | Electrospinning [82] |
| Silver nanoparticles (in situ synthesis by a chemical reduction method) | Lactobacillus plantarum | Sol-gel dip-coating process [26] |
| Silver-poly(acrylate) clusters | Staphylococcus aureus, Staphylococcus epidermidis, Pseudomonas aeruginosa, Candida albicans | Immersion in the polyacrylate dispersions [83] |
| Diamminesilver (I) silver [Ag(NH3)2]+ | Staphylococcus aureus and Escherichia coli | Sol-gel dip-coating process [84] |
| Silver nanoparticles (study as a function of the intensity and variation of the curing treatment) | Fungi (Aspergillus niger) and bacteria (Bacillus subtilis and Pseudomonas putili) | Sol-gel dip-coating process [85] |
| Silver containing silica sols | Escherichia coli | Pad-dry cure process; high long term-stability after washing cycles [86] |
| Silver and titanium oxide nanoparticles | Gram-negative bacteria (Escherichia coli); Gram-positive bacteria (Staphylococcus aureus); Fungi (Candida albicans) | Dip-coating process, Multifunctionality (UV protection and photocatalytic properties) [87] |
| Titanium oxide nanoparticles | Staphylococcus aureus and Escherichia coli | Sol-gel method [89]; Use of a binder to improve the durability after washing cycles |
| Metal oxide nanoparticles (ZnO, CuO and Fe2O3) | Gram-negative bacteria (Escherichia Coli and Pseudonomas aueginosa); Gram-positive bacteria (Staphylococcus aureus and Bacillus subtilis) | Sol-gel combustion method [90] |
| Metal oxide nanoparticles (ZnO) | Gram-negative bacterium (Escherichia coli); Gram-positive bacterium (Micrococus luteus) | Inorganic/organic hybrid coating polymer [91] |
| Silica coating embedding biocides (silver, silver salts and ammonium quaternarium salts) | Inhibition of bacteria (E. coli) and fungi (Aspergillus niger) | Long-term stability [92] |
| Silica nanoparticles combined with a high surface area | Lactobacillus plantarum | Layer-by-layer assembly [93] |
| In situ synthesis of silver nanoparticles | Escherichia coli, Staphylococcus aureus and Lactobacillus plantarum | Layer-by-layer technique [94] |
| Structuring Technique | Advantages | Disadvantages | Antibacterial Capacity | Scalability |
|---|---|---|---|---|
| Chemical Etching (Black Silicon) [101] | Biomimetic (nano-features similar to those observed in nature) | Material limitation (silicon); Time consuming (5 min-100 mm2 Surface area); Lack of control on pattern dimensions | P. aeruginasa: 4.3 × 105; S. aureus: 4.5 × 105; B. subtilis: 1.4 × 105 | ![]() |
| Hydrothermal treatments (Titanium nanowires) [102] | Size control (biomimetic) | Material limitation (Titanium); Time consuming (1 mm growth requires 1 h at 240 °C); Expensive process | S. aureus, E. faecali, K. pneumoniae: <10% (stain-dead cells); P. aeruginosa, E. coli, B. subtilis: 40% < ε < 80% (stain-dead cells) | ![]() |
| Pulsed Plasma Polymerization + UV irradiation(photolitography) [103] | Substrate independent method (polymeric coating); High resolution | Geometrical restrictions (planar surfaces); Photocurable polymeric materials are required; Time consuming process | E. coli: 13%–33% bacterial adhesion reduction after 14 h | ![]() |
| Direct laser interference patterning(DLIP) [104] | High quality nano-features in a wide range of materials | Limited to flat samples; Patterned dimensions depends on the laser characteristics (wavelength); Maximum area covered by this technology: 10–15 cm diameter (via Lloyd’s mirror) | S. aureus: up to 60% reduction in adhesion | ![]() |
| Electron Beam Evaporator [105] | Size control | Limited to a short range of materials (metals); Vacuum chamber and electron gun required; Expensive process. Small areas. | Decreased adhesion on S. aureus, epidermidis and aeruginosa (10% < ε < 40%, depending on the bacteria) | ![]() |
| Ultrashort pulsed laser ablation [106] | Hierarchical structures (micro and nano); Direct nanostructuring of a wide variety of materials; Possibility of large area structuring. | Nanoripples emerged more likely when metallic surfaces are considered; Time consuming; Expensive equipment (but robust and implemented in industrial environments). | On titanium. Decreased adhesion on
P. aeruginosa ≈ 90% No effects on S. aureus. | ![]() |
| Roll to roll Nanostructuring [107] | Replication of large areas via nanostructuring of the roll—die | Only suitable for nanostructuring flat polymeric films; Manufacturing in two steps: Nanostructuring of the roll and replication via roll to roll; Time consuming | E. coli: 32% reduction in bacterial adhesion, considering PS, PE and PC | ![]() |
: Good;
: Acceptable;
: Poor.| Deposition Technique | Sensing Parameter |
|---|---|
| Layer-by-layer assembly | pH (range 4–7); Good repeatability and high sensitivity [114] |
| Layer-by-layer assembly | Fast and linear response in either acid or alkali solution (pH range 2.5 to 10); Resolution of 0.013 pH unit [115] |
| Langmuir-Blodgett technique | Refractive index [116] |
| Radio-frequency plasma-enhanced chemical-vapor-deposited SiNx nanocoating | Refractive index and temperature [117] |
| Layer by-layer assembly | High sensitivities of 0.6 nm/pH unit and −0.85 nm/pH unit for acidic and alkaline solutions [119] |
| Layer-by-layer assembly | High accuracy of ±0.001 pH units; Average sensitivity of 0.027 pH units/nm (range between pH = 3 and pH = 6) [120] |
| Layer-by-layer assembly | Refractive index and chemical species; Fast response time [121] |
| Electrospinning | Gas sensing; High sensitivity and selectivity [122] |
| Sol-gel technology; core-shell silica nanoparticles | Dissolved oxygen; High sensitivity [123] |
| Layer-by-layer assembly | Relative Humidity [124] |
| Layer-by-layer assembly | Relative Humidity and temperature [125] |
| Layer-by-layer assembly | Refractive index [126] |
| Sol-gel method | Hydrofluoric acid in aqueous solutions (137) |
| Electrostatic self-assembly | LSPR sensing (gold nanospheres); DNA biosensor [138] |
| Ionic self-assembled multilayers (ISAM) technique | LSPR sensing (gold nanoparticles); Biotin-streptavidin bioconjugate pair [139] |
| Layer-by-layer assembly | LSPR sensing (gold nanoparticles); Antibody detection [140] |
| Layer-by-layer assembly | LSPR and LMR sensing (silver nanoparticles); Relative humidity changes [144] |
| Layer-by-layer assembly | LSPR and LMR sensing (gold nanoparticles); Refractive index changes [145] |
| Layer-by-layer assembly | LSPR and LMR sensing (gold nanorods); Refractive index and relative humidity changes [146] |
| Layer-by-layer assembly | LSPR and LMR sensing (gold nanorods); pH changes [147,148] |
| Layer-by-layer assembly | LSPR and LMR sensing (silver nanoparticles); Human breathing and relative humidity [149] |
© 2018 by the authors. Licensee MDPI, Basel, Switzerland. This article is an open access article distributed under the terms and conditions of the Creative Commons Attribution (CC BY) license (http://creativecommons.org/licenses/by/4.0/).
Share and Cite
Rivero, P.J.; Garcia, J.A.; Quintana, I.; Rodriguez, R. Design of Nanostructured Functional Coatings by Using Wet-Chemistry Methods. Coatings 2018, 8, 76. https://doi.org/10.3390/coatings8020076
Rivero PJ, Garcia JA, Quintana I, Rodriguez R. Design of Nanostructured Functional Coatings by Using Wet-Chemistry Methods. Coatings. 2018; 8(2):76. https://doi.org/10.3390/coatings8020076
Chicago/Turabian StyleRivero, Pedro J., Jose A. Garcia, Iban Quintana, and Rafael Rodriguez. 2018. "Design of Nanostructured Functional Coatings by Using Wet-Chemistry Methods" Coatings 8, no. 2: 76. https://doi.org/10.3390/coatings8020076
APA StyleRivero, P. J., Garcia, J. A., Quintana, I., & Rodriguez, R. (2018). Design of Nanostructured Functional Coatings by Using Wet-Chemistry Methods. Coatings, 8(2), 76. https://doi.org/10.3390/coatings8020076

